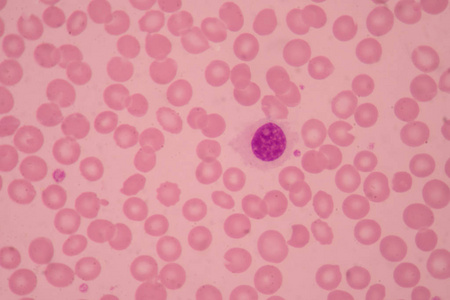
正常红细胞医学背景照片

正常红细胞
正常红细胞
图片尺寸1200x919
(图) 正常红细胞
图片尺寸1140x818正常红细胞
图片尺寸1200x827
正常红细胞(图片来源网络)
图片尺寸600x600
图为正常红细胞
图片尺寸1000x750血涂片中正常血红细胞.
图片尺寸1200x901
小红色粉红色正常红血细胞或红细胞照片
图片尺寸300x300
正常红细胞医学背景照片
图片尺寸450x300
黑背景一滴血检测仪下正常红细胞
图片尺寸1000x784红细胞
图片尺寸1200x799
红细胞滤过指数(if)
图片尺寸347x225
人的正常红细胞有多少?
图片尺寸600x428
小红色粉红色正常红血细胞或红细胞照片
图片尺寸298x300p>平均红细胞体积(mcv)是指人体单个红细胞的平均体积,以飞升(fl)为
图片尺寸1024x683红细胞
图片尺寸658x411
(图) 网织红细胞
图片尺寸1130x878人类红细胞的显微图片
图片尺寸1200x900红细胞
图片尺寸1200x800血涂片中正常血红细胞.
图片尺寸1200x847
正常白红细胞与镰刀型红胞 细
图片尺寸1080x810